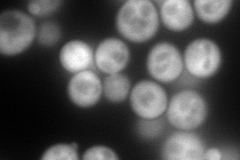
YER177W
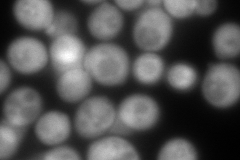
YER177W
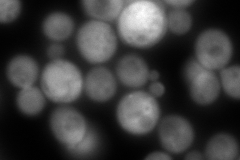
YER177W
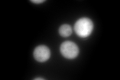
YER177W
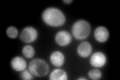
YER177W

View description
14-3-3 protein, major isoform; controls proteome at post-transcriptional level, binds proteins and DNA, involved in regulation of many processes including exocytosis, vesicle transport, Ras/MAPK signaling, and rapamycin-sensitive signaling
Localization:
Intensity:
Fold change:
Significance:
-
C’ GFP library in SD

cytosol606.5 -
N' NOP1pr-GFP in SD
cytosol306.529 -
N' TEF2pr-mCherry in SD
cytosol480.537 -
N' NATIVEpr-GFP in SD
cytosol529.917 -
N' TEF2pr-VC and Cyto-VN in SD

#N/A0 -
C’ GFP library in SD+DTT
cytosol917.241.51Yes -
C’ GFP library in SD+H2O2

cytosol774.511.27No -
C’ GFP library in Starvation Media
cytosol868.241.43No -
C’ GFP library on the background of Pup2-DaMP

cytosol -
C’ GFP library on the background of CCT mutant

cytosol655.8371.08134No
